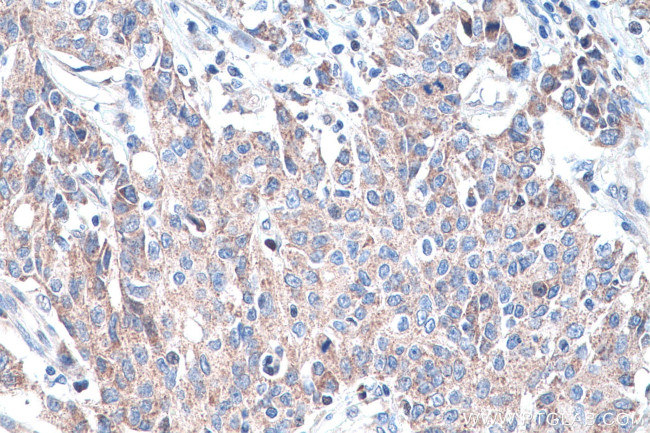
DNMT3A Antibody in Immunohistochemistry (Paraffin) (IHC (P))

Search
Proteintech
DNMT3A Polyclonal Antibody
{{$productOrderCtrl.translations['antibody.pdp.commerceCard.promotion.promotions']}}
{{$productOrderCtrl.translations['antibody.pdp.commerceCard.promotion.viewpromo']}}
{{$productOrderCtrl.translations['antibody.pdp.commerceCard.promotion.promocode']}}: {{promo.promoCode}} {{promo.promoTitle}} {{promo.promoDescription}}. {{$productOrderCtrl.translations['antibody.pdp.commerceCard.promotion.learnmore']}}
产品信息
20954-1-AP
种属反应
已发表种属
宿主/亚型
分类
类型
抗原
偶联物
形式
浓度
规格
纯化类型
保存液
内含物
保存条件
运输条件
产品详细信息
This antibody was raised against the N-terminal region of human DNMT3a. It is expected to detect the 120-130 kDa DNMT3a but not 72-100 kDa DNMT3a2.
Immunogen sequence: MPAMPSSGP GDTSSSAAER EEDRKDGEEQ EEPRGKEERQ EPSTTARKVG RPGRKRKHPP VESGDTPKDP AVISKSPSMA QDSGASELLP NGDLEKRSEP QPEEGSPAGG QKGGAPAEGE GAAETLPEAS RAVENGCCTP KEGRGAPAEA GKEQKETNIE SMKMEGSRGR LRGGLGWESS LRQRPMPRLT FQAGDPYYIS KRKRDEWLAR WKREAEKKAK VIAGMNAVEE NQGPGESQKV EEASPPAVQQ PTDPASPTVA TTPEPVGSDA GDKNATKAGD D (1-280 aa encoded by BC043617)
靶标信息
Methylation of DNA at cytosine residues plays an important role in regulation of gene expression, genomic imprinting and is essential for mammalian development. Hypermethylation of CpG islands in tumor suppressor genes or hypomethylation of bulk genomic DNA may be linked with development of cancer. To date, 3 families of mammalian DNA methyltransferase genes have been identified which include Dnmt1, Dnmt2 and Dnmt3. Dnmt1 is constitutively expressed in proliferating cells and inactivation of this gene causes global demethylation of genomic DNA and embryonic lethality. Dnmt2 is expressed at low levels in adult tissues and its inactivation does not affect DNA methylation or maintenance of methylation. The Dnmt3 family members, Dnmt3a and Dnmt3b, are strongly expressed in ES cells but their expression is down regulated in differentiating ES cells and is low in adult somatic tissue. Recently, it has been shown that naturally occurring mutations of Dnmt3b gene occurs in patients with a rare autosomal recessive disorder, termed ICF (immunodeficiency, centromeric instability, and facial anomalies) syndrome.
仅用于科研。不用于诊断过程。未经明确授权不得转售。
生物信息学
蛋白别名: AU015806; Cysteine methyltransferase DNMT3A; DNA (cytosine-5)-methyltransferase 3A; DNA (cytosine-5-)-methyltransferase 3 alpha; DNA cytosine methyltransferase 3A2; DNA methyltransferase 3A; DNA methyltransferase HsaIIIA; DNA methyltransferase MmuIIIA; DNA MTase HsaIIIA; DNA MTase MmuIIIA; Dnmt3a; W91664
基因别名: DNMT3A; DNMT3A2; HESJAS; M.HsaIIIA; MmuIIIA; TBRS
UniProt ID: (Human) Q9Y6K1, (Mouse) O88508, (Rat) Q1LZ53
Entrez Gene ID: (Human) 1788, (Mouse) 13435, (Rat) 444984